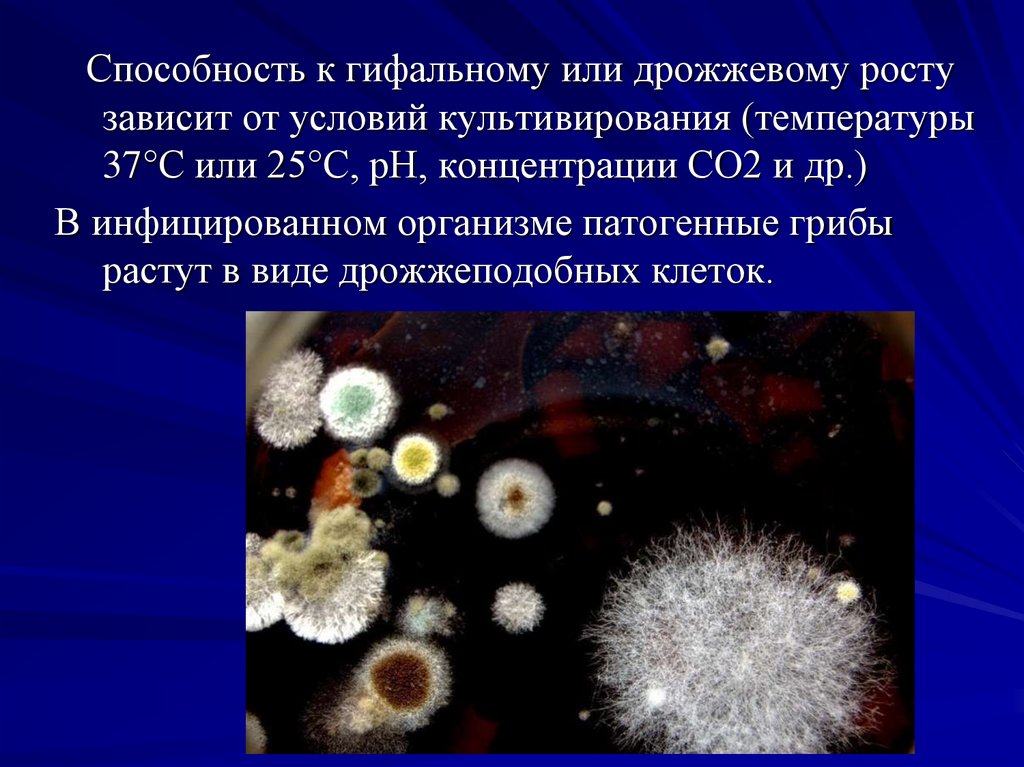
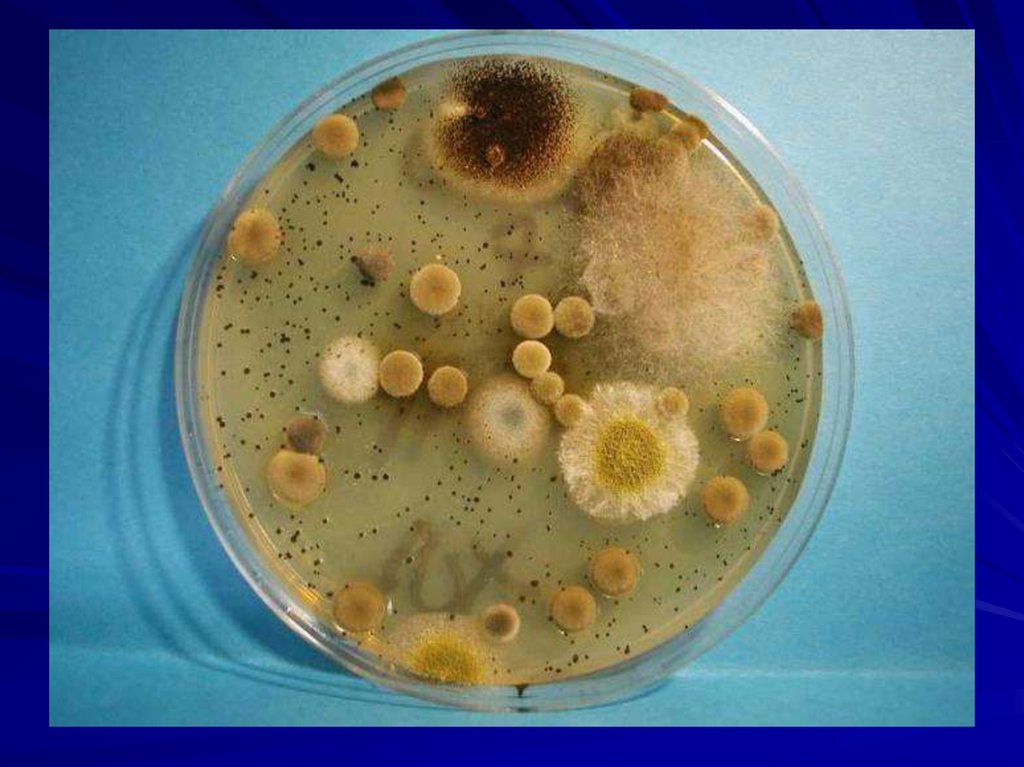
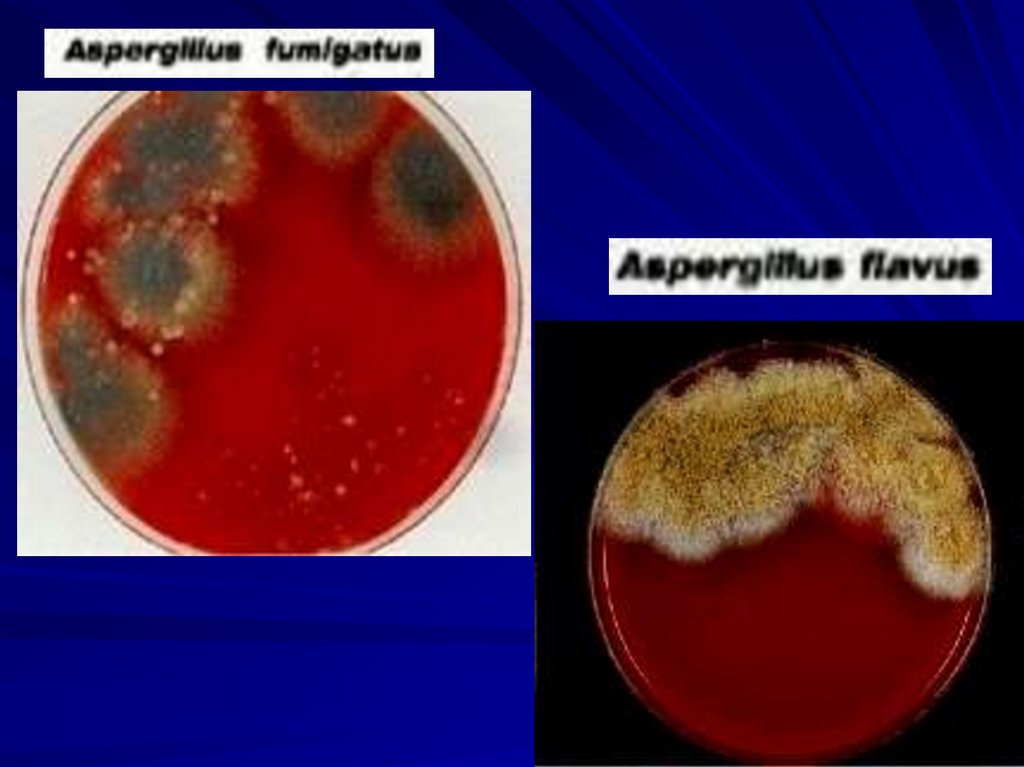
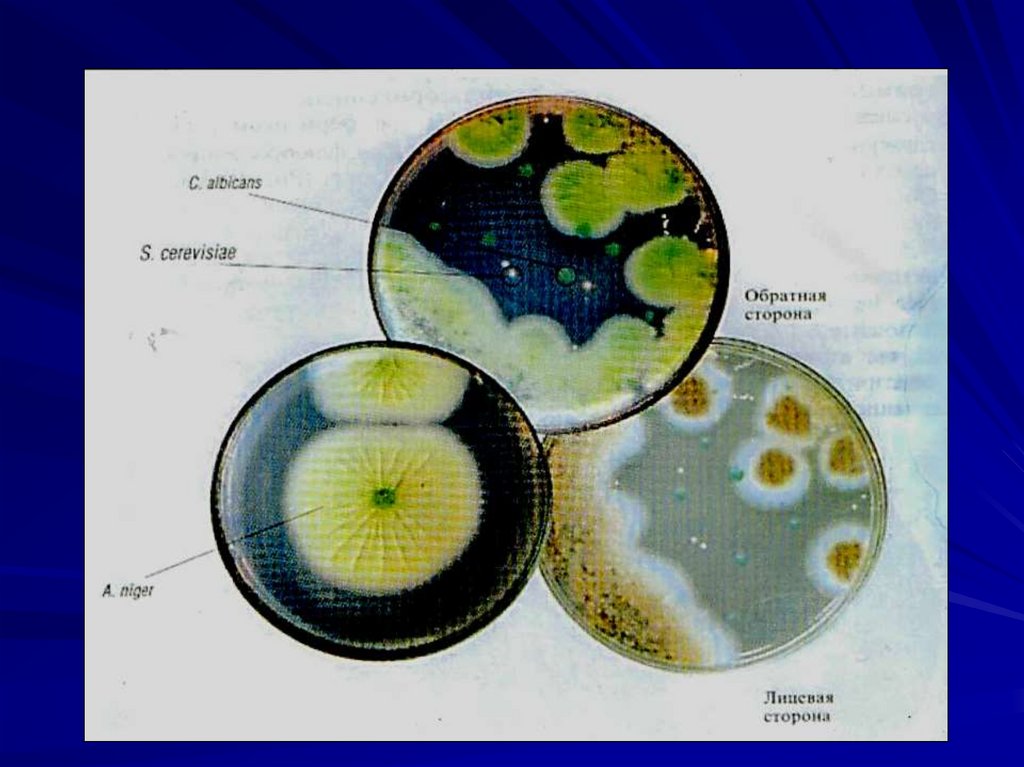

Similar presentations:
презентация 116 грр
1. Микроскопические грибы.
Зав.кафедройд.м.н., профессор
Г.И.Чубенко
2.
Из 70 тысяч видовмикроскопических
грибов около 300 патогенны для
человека и животных.
3. Общая характеристика
Многоклеточные или одноклеточныемикроорганизмы с признаками растений и
животных
Нефотосинтезирующие (бесхлорофильные)
эукариоты
Имеют клеточную стенку
Грамположительны
Запас углеводов в форме гликогена
Периферический рост
аэробы
4.
В основу систематики грибов положенобольшое разнообразие способов и органов
их размножения.
5. Царство: Mycota (Fungi) Отряд: Mycomycota Eumycota
Классы грибов:Chitridiomycetes
Zygomycetes
Ascomycetes
Basidiomycetes
Deuteromycetes
6.
7. Морфология
Клетки гриба окружены многослойной ригиднойклеточной стенкой и ЦПМ.
Клеточная стенка содержит несколько типов
полисахаридов (мананы, глюканы, целлюлозу, хитин), а
также липиды и белок.
ЦПМ содержит гликопротеины и в качестве основных
стероидов - эргостерол и зимэстрол.
Имеют оформленное ядро.
8.
9. Морфологические формы
ДиморфизмГифальная (плесневые грибы)
Клетки гриба- гифы, тонкие ветвящиеся
нити, сплетаясь образуют грибницу
(мицелий).
Толщина гиф колеблется от 2 до 100 мкм.
Гифы могут врастать в субстрат и
образовывать вегетативный мицелий,
который отвечает за питание гриба.
Гифы, растущие над поверхностью
субстрата, формируют воздушный или
репродуктивный мицелий (отвечают за
размножение).
10.
Гифы высших грибов разделены перегородками(септами), которые имеют поры.
Гифы низших грибов не имеют перегородок. Они
являются многоядерными клетками и называются
ценоцитными
(от греч. koenos-общий, единый).
11.
12.
Дрожжевая формаКлетки грибов имеют округлую форму, образуют
псевдогифы, состоящие из цепочек удлиненных
овоидных клеток.
При размножении образуют почки, имеют
бесполое деление, часто формируют ложный
мицелий.
13.
Грибы подобные дрожжам и не имеющиеполового размножения называют
дрожжеподобными.
14.
Способность к гифальному или дрожжевому ростузависит от условий культивирования (температуры
37°C или 25°C, рН, концентрации СО2 и др.)
В инфицированном организме патогенные грибы
растут в виде дрожжеподобных клеток.
15.
16. Резистентность
Грибы устойчивы к действию физических ихимических факторов.
Прямой солнечный свет ингибирует рост в культуре.
Малочувствительны к умеренному ультрафиолету и
рентгеновскому излучению. Облучение в низких
дозах- стимулирует рост.
Вегетативные клетки- некислотоустойчивы.
Выраженным фунгицидным действием обладает 3-5%
уксусная кислота, салициловая кислота, бензойные
кислоты, 5% раствор хлорной извести, 1-10%
формалин.
17. Размножение
Половое (гаметы, половые споры)бесполое (бесполые споры)
вегетативное (фрагментация, почкование).
Половой способ размножения имеют
зигомицеты, аскомицеты, базидиомицеты.
Только бесполый тип размножения имеют
дейтеромицеты.
18.
Половые формы гриба получили названиетелеморфы.Бесполые формы грибов назвали
анаморфами.
19.
Спорообразующие структуры грибовназываются спорофорами.
Терминальный конец спорофоры увеличивается по мере
роста в размере, а затем превращается в закрытое
вместилище спор- спорангий и содержит спорангиеспоры
или эндоспоры.
У некоторых грибов спорангиеспоры имеют жгутики, тогда
они называются зооспорами, а спорангии зооспорангиями.
20.
Спорофоры, формирующие свободные споры,называются конидиефорами (или конидиеносцами), а
свободные споры называются экзоспорами
или конидиями.
Конидиеносцы представляет собой особые ветви
мицелия, отличающиеся по строению и характеру
ветвления от остальных гиф.
21.
22.
Для некоторых видов грибов характерно тесноесплетение нескольких конидиеносцев в пучок. Такое
сплетение называется коремией.
Есть грибы конидиеносцы у которых заключены в
округлое тело – пикниду. Она имеет твердую оболочку
и узкое отверстие наверху для выхода конидий.
Пикнида защищает конидиеносцы и конидии от
неблагоприятных воздействий внешней среды.
23. Типы экзогенных спор:
Артроконидии образуются путем равномерногосептирования и расчленения гиф
Бластоконидии- в результате почкования образуются
бластоспоры с толстой оболочкой
Конидиоспоры- зрелые наружные споры
Микроконидии- одноклеточные малые споры.
Макроконидии- многоклеточные крупные споры.
а - оидии; б - конидии;
в - спорангии
24.
У некоторых грибов для размножения служат:• склероции – твердые образования из
уплотненных гиф; продолговатые или округлые
покоящиеся формы, способствующие их
выживанию в неблагоприятных условиях.
25.
Склероции имеют толстую, плотную оболочку(толстостенные и тёмные клетки) и сердцевину
(тонкостенные бесцветные клетки), гифы которой
богаты резервными материалами и особенно маслами.
Они содержат очень малое количество воды (5—10%)
и могут сохраняться долго в совершенно сухой среде,
не теряя способности прорастать — до нескольких лет.
26.
В большинстве случаев склероций состоитисключительно из грибных гиф,
Некоторые могут состоять частично из
сплетения гиф и частично из находящихся между
ними тканей самого субстрата (спорынья,
склеротиния).
Размеры склероция варьируют.
В благоприятных условиях склероций прорастает,
образуя грибницу с конидиями (у несовершенных
грибов).
27.
• хламидоспоры – уплотненные, покрытыетолстой оболочкой участки гиф. Они достаточно
устойчивы и способны перезимовывать.
28.
Хламидоспоры -толстостенные крупные покоящиесяклетки или комплекс мелких клеток.
29.
• Бесполые споры образуются при благоприятныхусловиях и служат для распространения вида.
• Половые споры устойчивы к неблагоприятным
воздействиям. Они образуются в меньшем
количестве и служат для сохранения вида
(например, для перезимовывания).
30.
Половые споры образуются в результатеслияния двух клеток. Слияние может быть
изогамное (слияние одинаковых клеток) и
оогамное (слияние женской и мужской половых
клеток).
В первом случае возникает зигоспора, , во
втором - ооспора.
31.
Зигоспоры- верхушки близко расположенных гифсливаются, в результате мейоза образуются крупные
зигоспоры с толстыми стенками, из которых
возникают спорангии, наполненный эндоспорами.
32.
Базидиоспоры являются органамиполового спороношения.
Происходит кариогамия — слияние ядер дикариона с
образованием зиготы, которая без периода покоя
делится мейотически. Образовавшиеся при этом 4
гаплоидные клетки становятся базидиоспорами, а клетка
которой они возникли - базидией.
Обычно базидиоспоры располагаются на маленьких и
тонких выростах базидии - стеригмах.
33.
Типы базидий:Холобазидии имеют булавовидную форму и
одноклеточное строение.
Гетеробазидии состоят из расширенной нижней
части — гипобазидии и верхней — эпибазидии,
являющейся выростом гипобазидии.
Фрагмобазидии, или телиобазидии, образуются из
толстостенной покоящейся клетки путём образования
поперечных перегородок, делящих её на четыре
клетки. По бокам от этих клеток развиваются
базидиоспоры.
34.
35. Класс Хитридиомицеты
(греч. капелька). Архимицеты.Одноклеточные грибы, преимущественно водные.
Около 500 видов. Паразитируют на водорослях,
простейших, беспозвоночных, редко на наземных
растениях и почве.
36.
Зачаточный мицелий, клетки в виде протопластов снесколькими ядрами.
Тело гриба таллома(слоевище) из которого вырастают
ризоидные гифы. В клеточной стенке содержатся
хитин-глюканы.
Бесполое размножение гаплоидными зооспорами с
одним жгутиком. Половое размножение: изо-, гетеро-,
оогаметы.
37. Класс Зигомицеты
[от греч. zygon, сочленение, + mykes, гриб]объединяет 10 порядков, 27 семейств, около 170 родов
и более 1000 видов.
Представлены быстрорастущим видами, обычно
обитающими в почве.
Отличаются развитым ценоцитным мицелием
непостоянной толщины, в котором септы образуются
только для отделения репродуктивных органов.
38. зигомицеты
Низшие грибы, размножение половое ибесполое.
При половом размножении образуются зигоспоры.
При бесполом- на плодоносящей гифе спорангии
находятся многочисленные спорангиеспоры.
39. зигомицеты
Представители родов:Rhizopus, Mucor, Rhizomucor, Absidia, Conidiobolus
и др.
40.
Мицелий зигомицетов имеет два знака («+» и «-»).При контакте противоположных мицелиев (слиянии
клеток на их концах — зигогамии),
формируется зигота, после мейоза, дающая
зачаточный мицелий со спорангием, в котором
развиваются споры полового спороношения, дающие
вегетативный мицелий разных знаков.
41.
Зигомицеты вегетативно распространяютсястолонами — выбрасываемыми в воздушную
среду длинными гифами, которые находят
подходящий субстрат и выпускают ризоиды,
давая начало новой колонии.
42.
Некоторые зигомицеты способнывызывать вторичные инфекции человека.
Тропические роды могут вызывать грануломатоз.
43.
Используются как продуцентыразличных веществ.
Rhizopus stolonifer
- получение фумаровой кислоты,
R. oryzae — спиртов,
Blakeslea trispora —
β-каротина,
44. Класс Аскомицеты
[от греч. askos, сумка, + mykes, гриб] 30 000 видов.Обитают в почве, на растениях, паразиты человека
и животных.
Гифы имеют выраженные перегородки с порами.
Клетки одно и многоядерные.
Основной орган плодоношения — сумка,
содержащей 4 или 8 гаплоидных половых
аскоспор.
Размножаются и бесполым путём (через
формирование конидий).
45. Аскомицеты
Представители родов:Saccharomyces, Arthroderma, Aspergills, Penicillium,
Fusarium и др.
46.
47.
В зависимости от места расположения сумок ихарактера их образования выделяют три подкласса:
1) голосумчатые, или гемиаскомицеты, у которых
отсутствуют плодовые тела и сумки располагаются по
одиночке или слоями на мицелии;
2) плодосумчатые, или эуаскомицеты, у которых
сумки образуются в настоящих плодовых телах
(аскокарпах);
3) полостносумчатые, у которых сумки расположены в
особых камерах локулах — полостях, возникающих в
строме.
48.
Возбудителям микозов человека выступаютпредставителей родов Geotrichum, Microsporum и
Trichophyton.
49.
Сахаромицеты- род из класса аскомицетов.Обитают в богатых сахарами субстратах, являются
возбудителями спиртового брожения. Не обладают патоген
ными свойствами. Размножаются почкованием.
Псевдомицелия не образуют. В неблагоприятных
условиях возникают артроспоры и сумки со спорами.
50. Класс Дейтеромицеты
[от греч. deuteros, вторичный, + mykes, гриб]формальная группа грибов, около 30% всех
известных видов (25 тыс. видов).
Несовершеные грибы, не имеющие полового
размножения, либо половая стадия размножения не
выявлена.
Весь жизненный цикл проходит в
гаплоидной стадии.
51.
Deuteromycetes имеют многоклеточный, хорошоразвитый мицелий.
Спороношение — бесполое, конидиальное.
В зависимости от характера конидиального
спороношения их разделяют на три порядка:
гифомицеты,
меланкониальные
сферопсидальные.
52.
53.
У многих представителей в цикле их развитияформируются две конидиальные стадии
(например, макроконидии и микроконидии).
54.
Многие дейтеромицеты образуют конидиеносцы,объединенные в группы на мицелии или внутри
пикнид.
Простейшая форма такой аггрегации конидиеносцев коремии.
55.
Большая часть возбудителей микозов человека входит вгруппу несовершенных грибов.
В почве имеются многие представители данного
порядка — Cephalosporium, Trichoderma,
Cladosporium, Alternaria, Fusarium и др
56.
Дейтеромицеты представители родов:Cryptococcus, Malassezia, Coccidioides, Sporpthrix,
Fonsecaea и др.
57. Класс Базидиомицеты
[от греч. basidon, маленькая основа, + mykes, гриб]объединяет около 30 тысяч видов.
Имеют характерный орган спороношения — базидий.
На базидии путём мейотического деления
развиваются, отшнуровываясь от него,
базидиоспоры.
58.
В морфологии базидий выделяют три основные части:тело, которое может быть одноклеточным или
состоять из нескольких клеток — гаплоцитов;
стеригмы — узкие выросты, число которых равно
числу производимых базидией спор;
базидиоспоры.
Стеригмы обычно имеют форму узкого конуса, часто
расположены на верхушке цилиндрической или
булавовидной базидии, но могут образовываться и на
боковых поверхностях. У многоклеточных базидий
каждый гаплоцит формирует одну стеригму.
59.
60.
• Мицелий базидиомицетов септирован,каждая клетка содержит по 2 гаплоидных ядра.
• Обычно ядра расположены рядом посередине клетки,
их пара носит название дикарион.
• Возле септы у гифов базидиомицетов
формируется пряжка, участвующая в делении клетки.
Пряжка — тонкий вырост из одной клетки гриба,
примыкающий к другой соседней клетке, но не
сливающийся с ней.
• При делении клетки ядра синхронно удваиваются и
пряжка позволяет оказаться в одной клетке ядрам,
сформировавшимся из разных исходных.
61.
62.
Единственным облигатным патогенном для человекавыступает Filobasidiella neoformans (половая форма
Cryptococcus neoformans var. neoformans).
63. Культивирование грибов
Грибы – гетеротрофы и нуждаются в дополнительныхфакторах роста, витаминах.
Для выращивания грибов используют среды: Сабуро,
Чапека, сусло-агар или жидкое пивное сусло,
картофельно-декстрозный агар.
Оптимальная рН 6,0-7,0. Средняя продолжительность
роста грибов 1-5 суток и более. Продолжительность
культивирования до 3-х недель и 2 месяцев.
По отношению к температуре культивирования грибы
являются мезофилами (25-45оС). Оптимальная
температура культивирования 22-28 оС.
64.
65.
66.
67.
68. Факторы патогенности микроскопических грибов
Токсические морфологические компоненты(полисахариды и липиды грибов);
Способность вырабатывать различные ферменты
(сахаролитические, протеолитические и
липолитические);
Способность вырабатывать ферменты инвазивности и
широкий спектр токсинов, которые оказывают
повреждающее воздействие на ткани макроорганизма
и клетки крови;
Способность вырабатывать пигменты, растворимые в
воде или спиртах. Повышающие резистентность
возбудителей, а также обладающие дополнительным
токсическим воздействием;
Сенсибилизирующая способность грибов (развитие
реакций ГНТ и ГЗТ).
69.
Важную роль на патогенез любых микозовоказывают нарушения обмена веществ и функции
эндокринной системы, гипо- и авитаминозы,
иммунодефициты различного происхождения,
возраст, особенности профессиональной
деятельности и др.
70.
Выделяют микозы:Первичные- вызывают облигатно патогенные
грибы (Histoplasma capsulatum, Coccidioides
immitis и др.),
вторичные- условно патогенные (представители
родов: Aspergillus, Candida, Mucor и др.).
71.
Возбудители системных или глубоких микозов(возбудители кокцидиоидоза, гистоплазмоза,
криптококкоза, бластомикоза);
возбудители подкожных (субкутанных) микозов
(возбудители споротрихоза, хромомикоза,
мадуромикоза);
возбудители эпидермомикозов, поражают эпидермис,
волосы, ногти);
возбудители поверхностных микозов (кератомикозы
– разноцветный лишай, трихоспороз и др.).
Поражают лишь роговой слой эпидермиса и волосы;
возбудители оппортунистических микозов вызывают
заболевания у людей и животных на фоне
иммунодефицитов, условно-патогенные грибы.
Возбудители микотоксикозов
72. Лабораторная диагностика микозов
Микроскопический- исследуют патологическийматериал- чешуйки кожи, волосы размягченные 10%
раствором NaOH. Обработанный щелочью материал
помещают на предметное стекло в каплю глицерина,
накрывают покровным стеклом,
Используют фазово-контрастную микроскопию, что
позволяет изучить строение гриба, расположение
спор.
73.
74.
Окончательное заключение делают послемикологического исследования.
Посевы инкубируют при температуре 25оС и 37оС.
От 2-х недель до 2 месяцев.
При идентификации учитывают форму колоний,
цвет, консистенцию и микроскопические данные.
75.
Серологическое исследование.При серологическом исследовании обнаруживают уже
через 2-4 недели АТ IgM и IgG в реакциях РСК, РА,РП,
ИФА. Нарастание титра комплементсвязывающих АТ
считается плохим прогностическим признаком и
говорит о генерализации инфекции.
Кожно-аллергический - постановка проб с
аллергенами в разведении 1:100 и 1:1000. Результат
учитывают через 48 часов.
76.
Биологический метод- для выделения грибаиспользуют внутрибрюшинное, подкожное и
интратестикулярное заражение мышей, крыс,
морских свинок.
Лечение этиотропное
77. Антимикотики
Азолы - нарушают синтез эргостерола (кетоконазол,миконазол, клотримазол, дифлюкан)
Алиламины - (тербинафин, нафтифин) нарушение
эргостерола
Морфолины - нарушение синтеза эргостерола
(аморфолин)
Полиеновые антибиотики- повреждение клеточной
стенки (нистатин, леворин, амфотерицин В)
Антиметаболиты - 5-фторцитозин, ингибирование
синтеза нуклеиновых кислот системных грибов
Гризеофульвин - нарушение микротубулярного
аппарата, блокирование размножения
78.
79. Возбудители микотоксикозов
Микотоксикозы- заболевания обусловленныепопаданием в организм токсинов грибов.
Обнаружено более 300 микотоксинов.
Наибольшее значение в патологии человека имеют 20.
80. Классы микотоксинов
Афлотоксины (spp.Aspergillus)Трихотецены (spp. Fusarium)
Охратоксины (spp. Aspergillus, spp. Penicillium)
Эрготоксины (spp. Claviceps )
Патулотоксины (spp. Penicillium)
81. Афлотоксикозы
Aspergillus fumigatusAspergillus flavus
Грибы развиваются на злаках (рис, кукуруза, ячмень,
пшеница) при повышенной влажности и температуре
от +10 до +40оС с образованием желтого или зеленого
налета.ПДК -5 мкг/кг, в кормах животных-20 мкг/кг.
82.
По химической природе- производные кумаринаАфлотоксин В1- нарушает обмен Са, витамина Д,
угнетает рост костей; индуцирует развитие карциномы
желудка, жировые некрозы гепатоцитов, первичный
рак печени
«чёрный» язык
83. Охратоксины
Образуются грибами рода Fusarium, Penicillum вдиапазоне температур от 0 до +30оС.
Поражают преимущественно почки. Нефропатии
сопровождаются анемиями, нарушением
концентрационной функции почек.
При длительном поступлении-опухоли почек и печени.
84. Трихотецены
Грибы: Fusarium sporotrichiella,Fusarium graminearum,
Fusarium nivaie
Развиваются на злаковых культурах и хлебобулочных
изделиях при высокой влажности и температуре от +3
до 12оС с образованием налета белого или розового
цвета
85.
Известно более 40 токсинов данной группы.Наибольшее значение имеют Т-2 и ТН-2.
Острое отравление проявляется через 30-60 минут:
рвота, диарея, слабость, скованность походки,
деструкция селезенки и вилочковой железы.
Хроническое- нарушение зрения, психики,
кроветворения (геморрагический синдром),
тератогенное и эмбриотоксическое действие, рак
пищевода
86. Эрготоксины
Claviceps paspali,Claviceps purpurae
Производные лизоргиновой кислоты и клавиновые
алкалоиды.
Эрготоксины- мощные галлюциногены, поражение
печени.
87. Патуллотоксины
Продуцируются грибами рода Penicillum при развитиина пищевых продуктах, варенье, хлебобулочных
изделиях.
Поражение почек, ЖКТ, печени, селезенки, индуцируют
развитие фибросарком.

biology
biology








